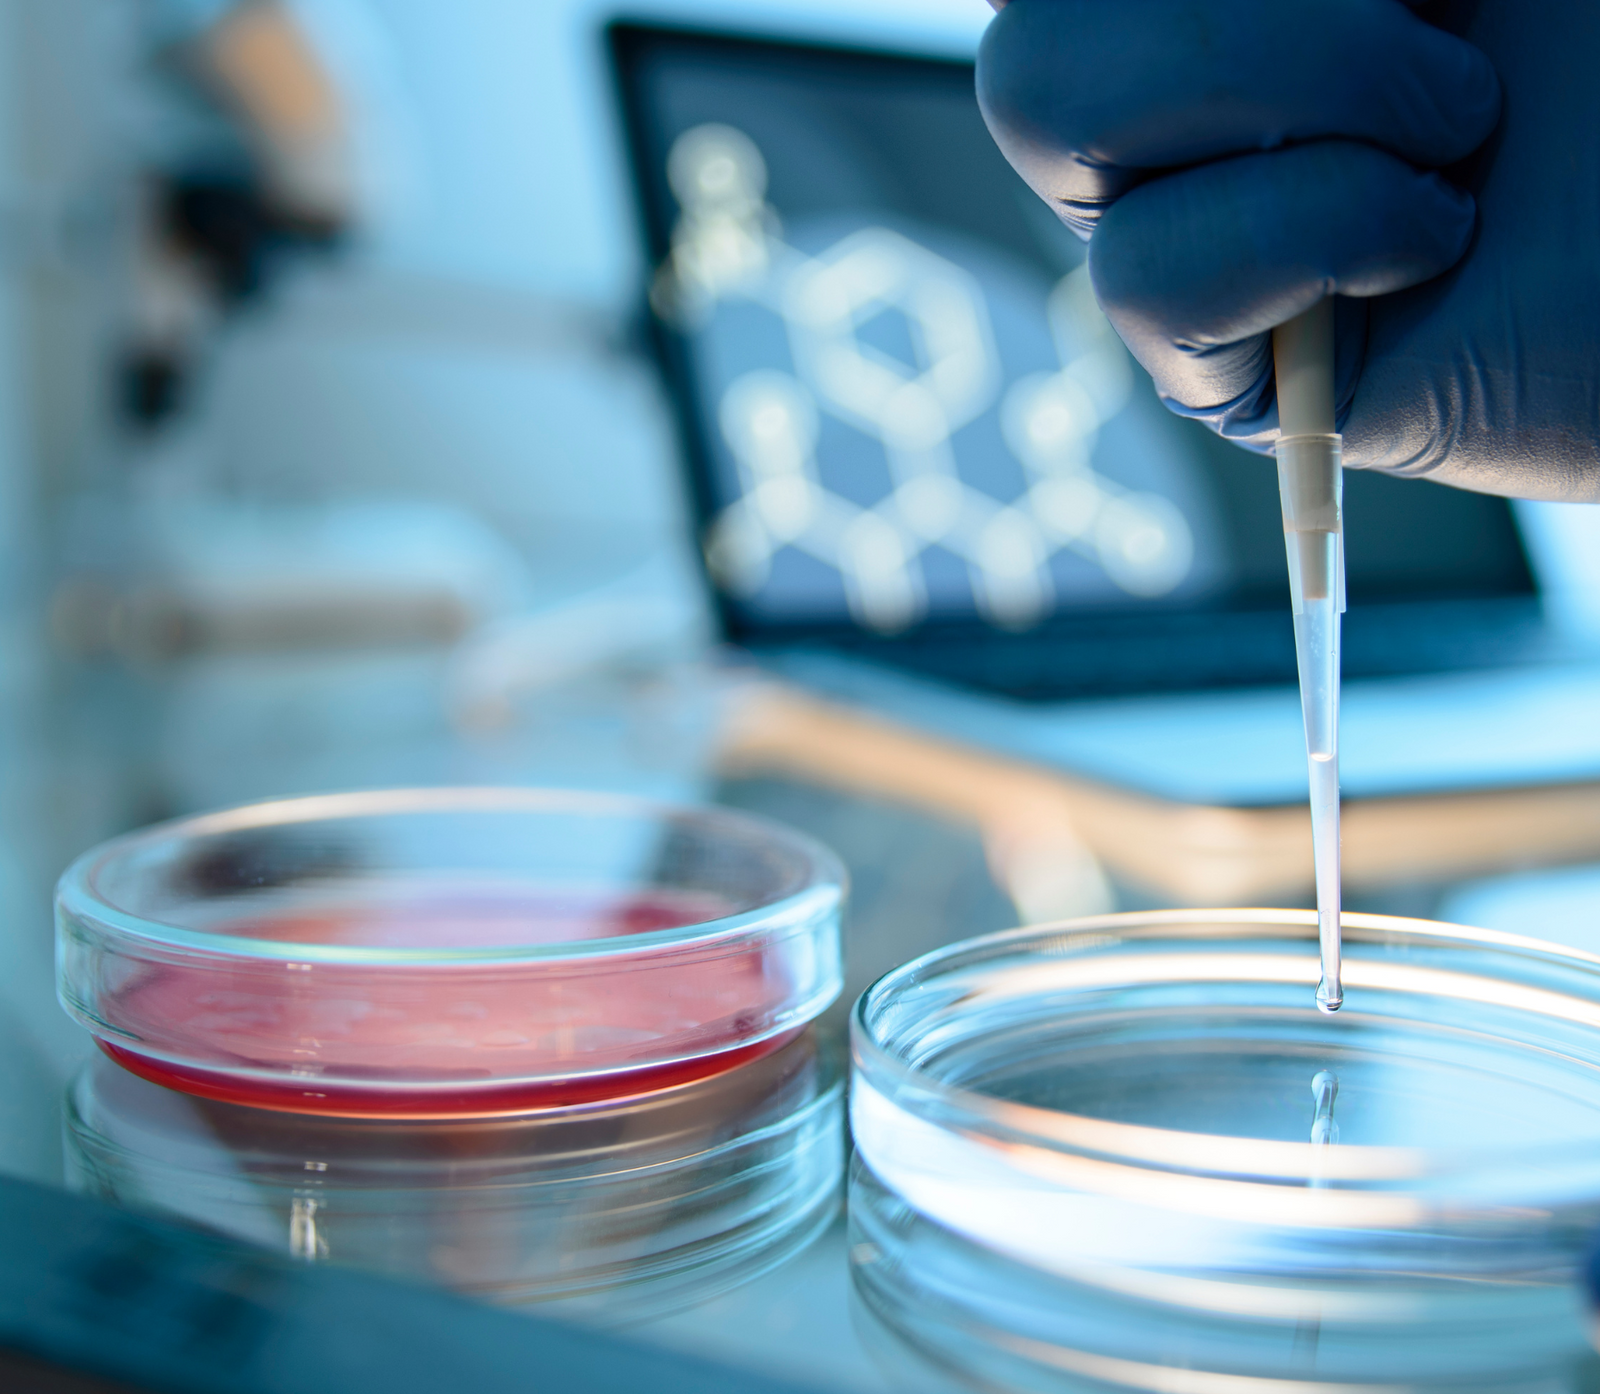

Nanotechnology is not new—neither is its application in drug delivery methods. It has helped vastly improve the bioavailability and targeted delivery of oral pharmaceutical applications for more than 30 years.
Due to a lack of manufacturers, worldwide, with the ability to stabilize and emulsify the particles with all-natural ingredients—while keeping them at the right size for safety and efficacy—it was left majorly untouched in the nutraceutical and dietary supplement space; until now.
Nanotechnology is not new—neither is its application in drug delivery methods. It has helped vastly improve the bioavailability and targeted delivery of oral pharmaceutical applications for more than 30 years.
Due to a lack of manufacturers, worldwide, with the ability to stabilize and emulsify the particles with all-natural ingredients—while keeping them at the right size for safety and efficacy—it was left majorly untouched in the nutraceutical and dietary supplement space; until now.
Our team of scientists and researchers were tasked with creating the most complete brain health nootropic in the world. One that absorbs quickly with full bioavailability in the human body, while adhering to the strictest safety, manufacturing, and efficacy standards. The tech, research, and science was all available to achieve this goal, but we wanted to go beyond what was out there. A year of research and third-party testing later, and EBH™ NanoCap™ was born.
Our team of scientists and researchers were tasked with creating the most complete brain health nootropic in the world. One that absorbs quickly with full bioavailability in the human body, while adhering to the strictest safety, manufacturing, and efficacy standards. The tech, research, and science was all available to achieve this goal, but we wanted to go beyond what was out there. A year of research and third-party testing later, and EBH™ NanoCap™ was born.
Learn more about the research that makes nanotechnology an unparalleled method in the dietary supplement and nutraceutical space.
----
Nanodelivery of Dietary Polyphenols for Therapeutic Applications
Advancement in nanotechnology has unleashed the therapeutic potentials of dietary polyphenols by enhancing bioavailability, improving biological half-life, and allowing site-specific drug delivery. In this review, through citation of relevant literature reports, we discuss the application of nano-pharmaceutical formulations, such as solid lipid nanoparticles, nano-emulsions, nano-crystals, nano-polymersomes, liposomes, ethosomes, phytosomes, and invasomes for dietary polyphenols.
Nanotechnology: An approach to overcome bioavailability challenges of nutraceuticals
Nanotechnology provides opportunities in all sectors of scientific investigation including health. Nutraceuticals address a quickly developing/emerging field in nano-research. In this study, extensive literature search was carried out on application of nanotechnology to overcome the bioavailability issues related to nutraceuticals in various scientific databases and compiled.
Nanotechnology: A novel tool to enhance the bioavailability of micronutrients
Nanotechnology has revolutionized the field of food systems, diagnostics, therapeutics, pharmaceuticals, the agriculture sector, and nutraceuticals. Nanoparticles are playing important role in giving the solution to enhance bioavailability of oral delivery of bioactive compounds. This review revealed that nanoparticles can improve the bioavailability of micronutrients.
Bioavailability of nanotechnology-based bioactives and nutraceuticals
Bioaccessibility and bioavailability of some hydrophobic bioactives (e.g., carotenoids, polyphenols, fat-soluble vitamins, phytosterols and fatty acids) are limited due to their low water solubility, and in some instances low chemical stability. Nanotechnology involving nanometric (r<500nm) delivery systems, can be used to improve the solubility and thus enhance the bioaccessibility and bioavailability of hydrophobic compounds.
Learn more about the research that makes nanotechnology an unparalleled method in the dietary supplement and nutraceutical space.
----
Nanodelivery of Dietary Polyphenols for Therapeutic Applications
Advancement in nanotechnology has unleashed the therapeutic potentials of dietary polyphenols by enhancing bioavailability, improving biological half-life, and allowing site-specific drug delivery. In this review, through citation of relevant literature reports, we discuss the application of nano-pharmaceutical formulations, such as solid lipid nanoparticles, nano-emulsions, nano-crystals, nano-polymersomes, liposomes, ethosomes, phytosomes, and invasomes for dietary polyphenols.
Nanotechnology: An approach to overcome bioavailability challenges of nutraceuticals
Nanotechnology provides opportunities in all sectors of scientific investigation including health. Nutraceuticals address a quickly developing/emerging field in nano-research. In this study, extensive literature search was carried out on application of nanotechnology to overcome the bioavailability issues related to nutraceuticals in various scientific databases and compiled.
Nanotechnology: A novel tool to enhance the bioavailability of micronutrients
Nanotechnology has revolutionized the field of food systems, diagnostics, therapeutics, pharmaceuticals, the agriculture sector, and nutraceuticals. Nanoparticles are playing important role in giving the solution to enhance bioavailability of oral delivery of bioactive compounds. This review revealed that nanoparticles can improve the bioavailability of micronutrients.
Bioavailability of nanotechnology-based bioactives and nutraceuticals
Bioaccessibility and bioavailability of some hydrophobic bioactives (e.g., carotenoids, polyphenols, fat-soluble vitamins, phytosterols and fatty acids) are limited due to their low water solubility, and in some instances low chemical stability. Nanotechnology involving nanometric (r<500nm) delivery systems, can be used to improve the solubility and thus enhance the bioaccessibility and bioavailability of hydrophobic compounds.